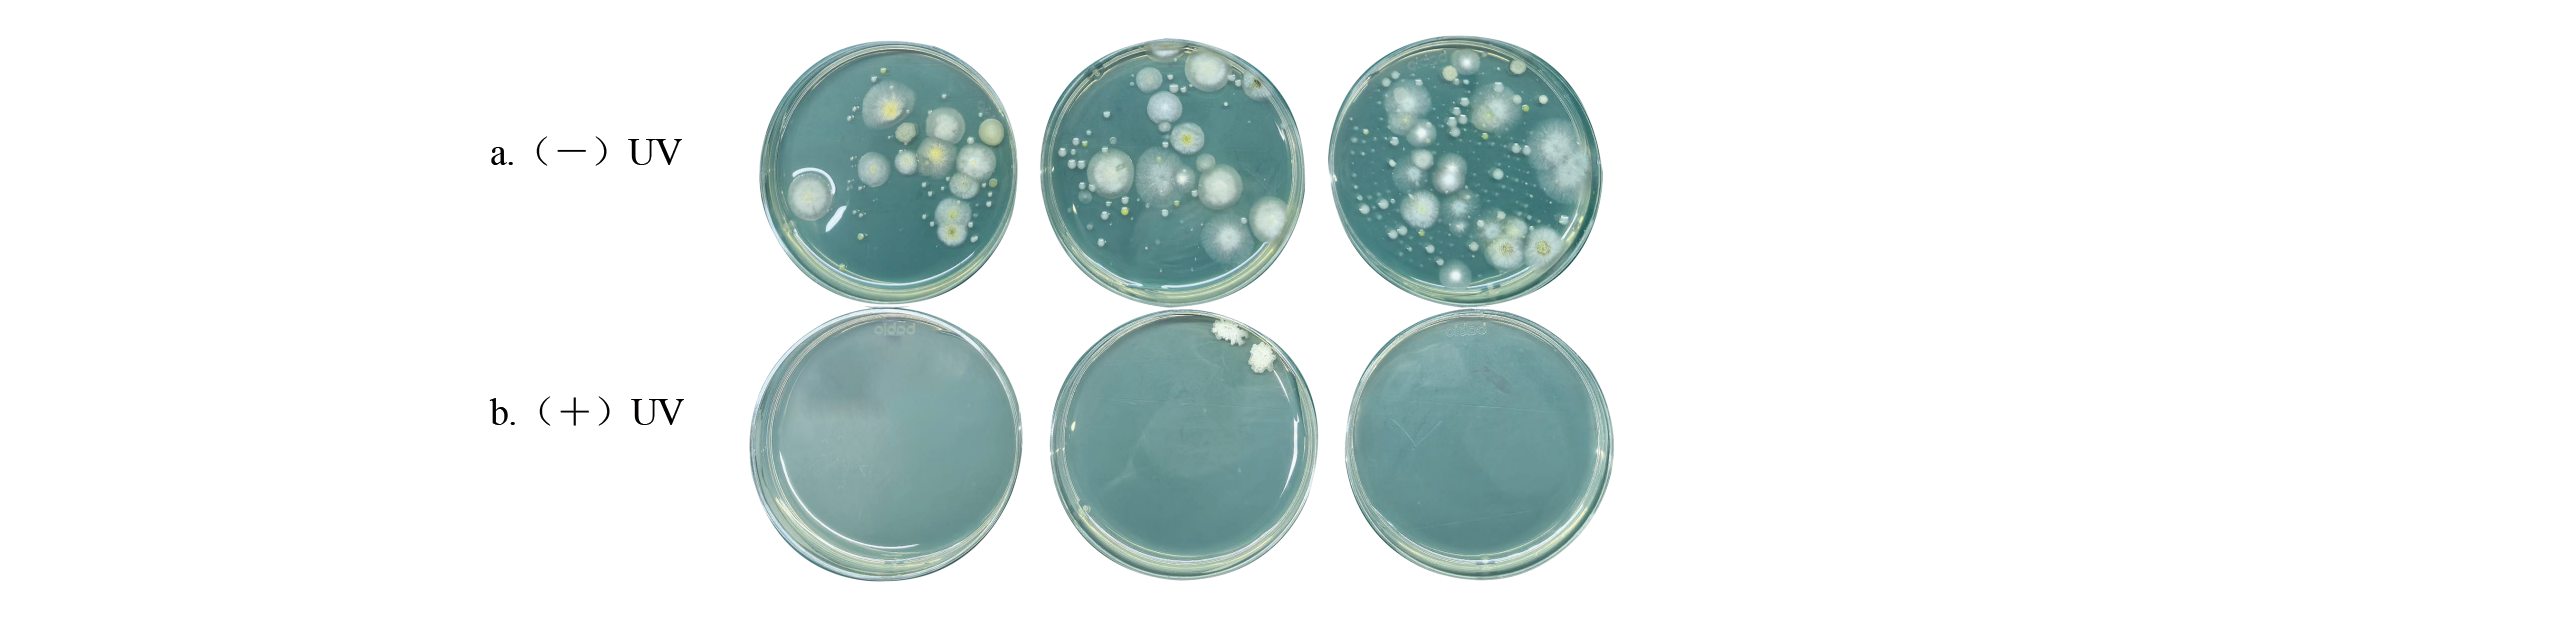
ISAIMS-口腔消毒器-A-دراسة-على-أداء-مطهر-الفم-القائم على-الأشعة فوق البنفسجية-C-LED-تكنولوجيا التطهير-5
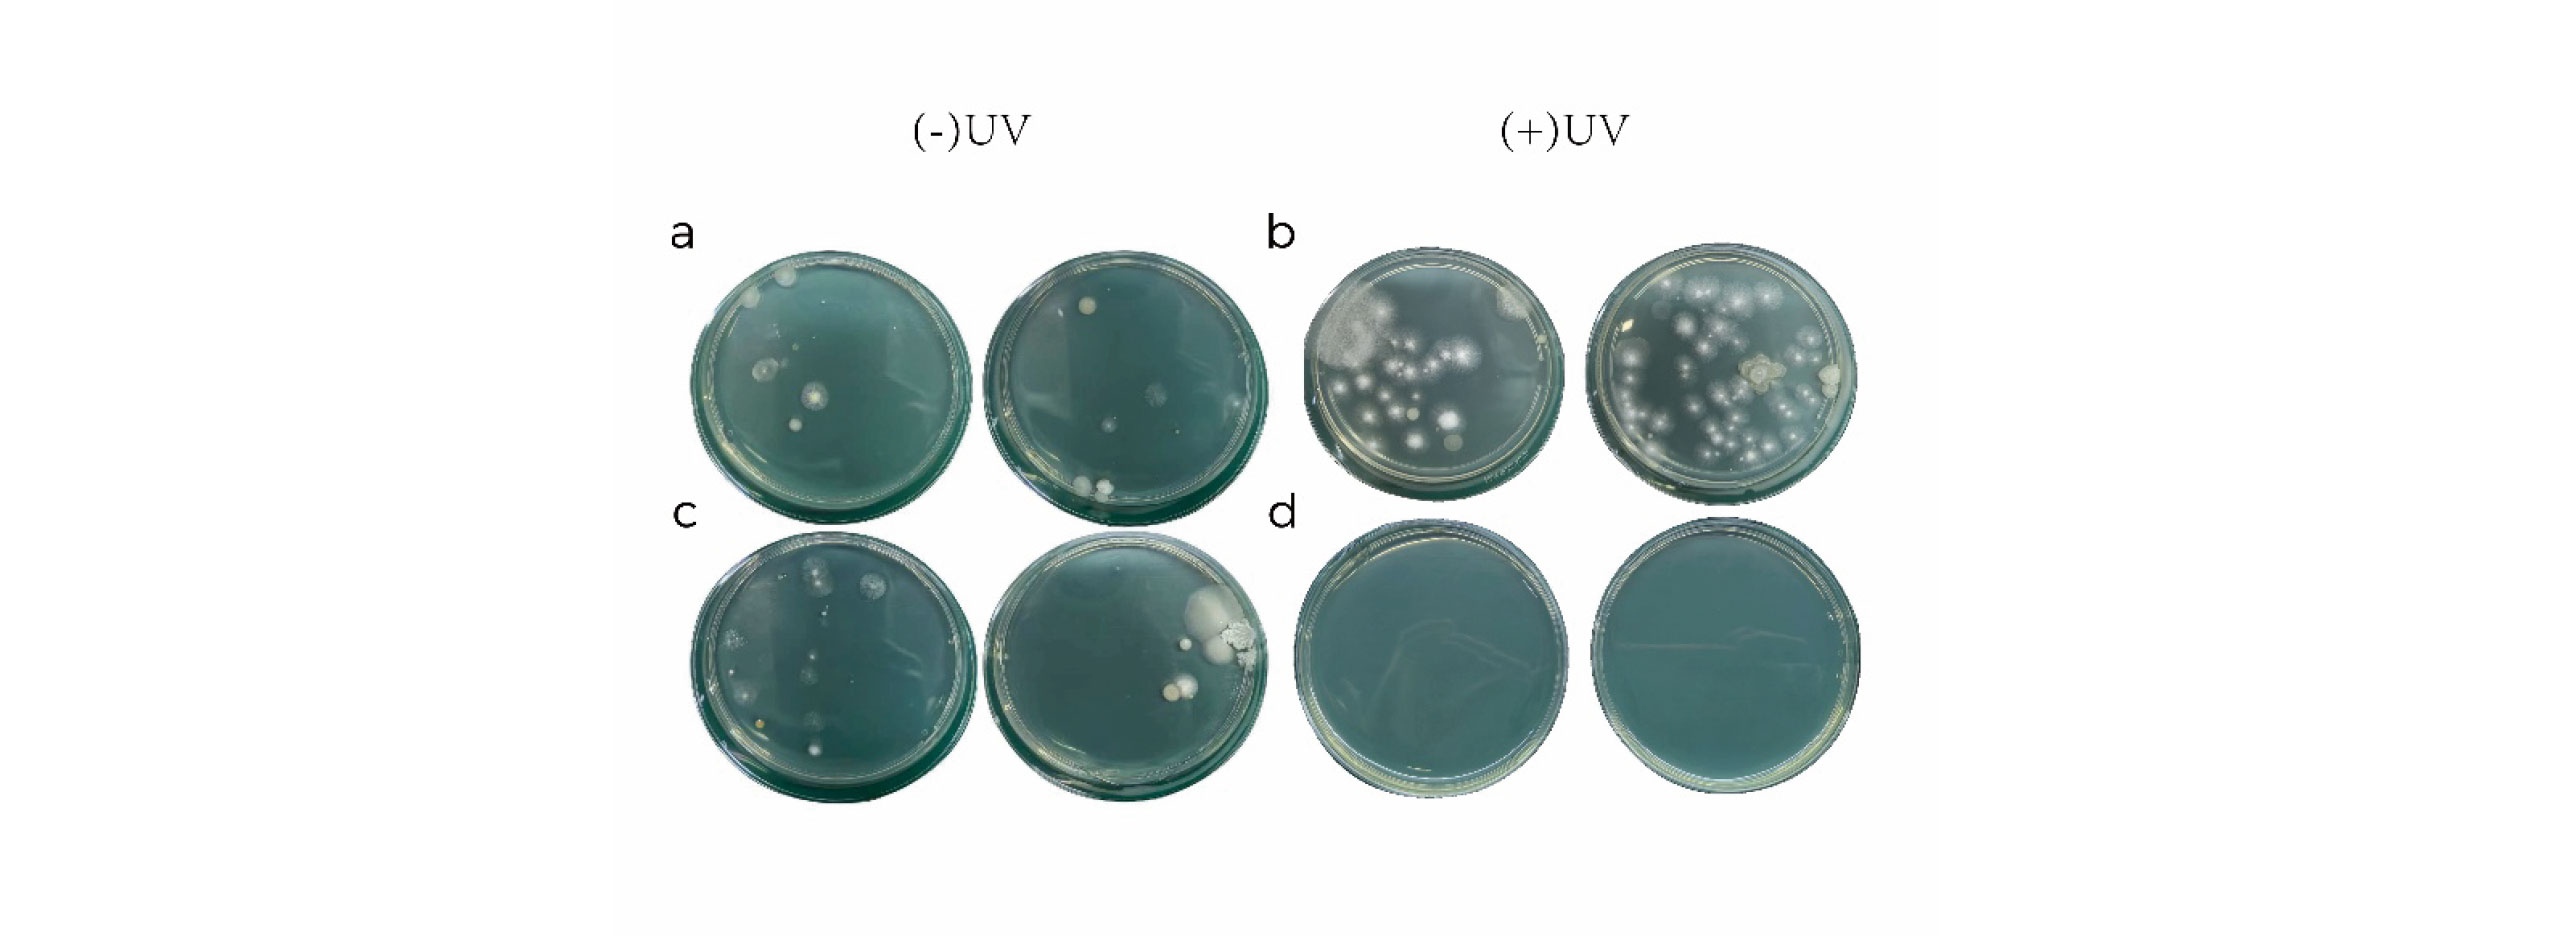
أهداف2025-108(1)-5

الكاتب:محرر الموقع نشر الوقت: 17-10-2025 المنشأ:محرر الموقع
إيسون لياو *
MASSPHOTON LIMITED هونج كونج، هونج كونج، HK1100، الصين، eason@massphoton.com
شياو شياو وانغ
MASSPHOTON LIMITED هونج كونج، هونج كونج، HK1100، الصين، sunny@massphoton.com
محمد فرقان
مستشفى تشيس فارم الخدمة الصحية الوطنية لندن، لندن، المملكة المتحدة.furqanl@nhs.net
محمد صفا
MASSPHOTON LIMITED هونج كونج، هونج كونج، HK1100، الصين، shafa@massphoton.com
شوزونغ لي
MASSPHOTON LIMITED هونج كونج، هونج كونج، HK1100، الصين، szl@massphoton.com
قوانغجين وانغ
MASSPHOTON LIMITED هونج كونج، هونج كونج، HK1100، الصين، gjw@massphoton.com
خلاصة
لقد حظيت تقنية LED UV-C LED باهتمام كبير كحل متطور للتحكم في انتشار الأمراض المعدية والوبائية. تدمج هذه الدراسة بشكل مبتكر تقنية UV-C LED في مطهر للفم، مما يؤدي إلى تطوير نظام لتطهير الهواء يعتمد على امتصاص الهواء الدائر. يلتقط النظام بشكل فعال القطرات والهباء الجوي المتولد أثناء التشخيص والعلاج عن طريق الفم، مما يحقق تعطيلًا فعالًا للميكروبات من خلال وحدة تعقيم LED مدمجة بالأشعة فوق البنفسجية. تم اختيار الإشريكية القولونية غير المسببة للأمراض والبكتيريا البيئية الطبيعية كمواضيع اختبار لمحاكاة سيناريوهات العلاج عن طريق الفم في العالم الحقيقي وتقييم كفاءة التعقيم. أظهرت النتائج أن المطهر يحقق معدل تعقيم يبلغ 97.22% للإشريكية القولونية و96.24% للبكتيريا الطبيعية، مما يدل على فعالية ممتازة في تطهير الهواء بالميكروبات. بالإضافة إلى ذلك، لضمان التشغيل الآمن، تم قياس شدة الإشعاع في ثلاثة مواقع رئيسية (يسار، وسط، يمين) حول المطهر، مما يؤكد عدم وجود خطر تسرب للأشعة فوق البنفسجية أثناء التشغيل. تمثل هذه الدراسة استكشافًا منهجيًا لتقنية التطهير UV-C LED في الإعدادات السريرية الفموية المحاكاة، مما يوفر دعمًا مهمًا للبيانات لتعطيل الهباء الحيوي ويقدم أسس نظرية وعملية لتطوير تقنيات مكافحة العدوى في بيئات الرعاية الصحية عن طريق الفم.
الكلمات الرئيسية
UV-C LED، مطهر الفم، تعقيم الهواء، الهباء الجوي، الإشريكية القولونية، الوقاية
تنسيق مرجع ACM:
إيسون لياو، وشياوكسياو وانغ، ومحمد فرقان، ومحمد شافا، وشوزونغ لي، وجوانجين وانغ. 2025. دراسة عن الأداء
∗المؤلف المقابل.
1 مقدمة
مع التحسن المستمر في مستويات المعيشة والوعي الصحي والتصورات الجمالية، هناك تركيز متزايد على جماليات الأسنان وصحة الفم، مما يؤدي إلى زيادة يومية في الأفراد الذين يبحثون عن رعاية روتينية للفم والمرضى الذين يعانون من أمراض الفم. ومع ذلك، فإن عملية التشخيص والعلاج عن طريق الفم تظهر خصائص مميزة مقارنة بجودة تشخيص الأمراض الأخرى. أدوات مثل مرايا الأسنان التي يستخدمها الأطباء أثناء فحوصات الفم، والقبضات عالية السرعة المستخدمة بشكل متكرر في إجراءات طب الأسنان، وأجهزة العلاج بالموجات فوق الصوتية تولد قطرات من لعاب المرضى ودمهم ومواد أخرى أثناء العملية. تمتزج هذه القطرات مع جزيئات الغبار المحمولة جواً لتشكل الهباء الجوي الذي يظل معلقًا في الهواء [1-3]. من بينها، يبقى الهباء الجوي الأصغر حجمًا معلقًا في الهواء لفترات طويلة قبل أن يترسب على الأسطح البيئية أو يدخل جسم الإنسان عن طريق التنفس [4، 5]؛ تتبع القطرات الأكبر عادةً مسارات باليستية ولا يزال من الممكن اكتشافها على مسافات تتراوح بين 2-4 أمتار من موقع العلاج [6]، على الرغم من أن تركيزها يتضاءل مع زيادة المسافة من مصدر التلوث [7، 8]. وتزيد جزيئات الهباء الجوي التي تحمل فيروسات معدية من خطر الإصابة بالعدوى للعاملين في أقسام طب الأسنان.
حاليًا، تركز طرق تطهير الهواء المعتمدة في مختلف أقسام المستشفيات بشكل أساسي على تنقية الهواء في الطبقة العليا بشكل عام داخل العيادة [9]. تثبت أجهزة تنقية الهواء الموجودة فعالية مبيد للجراثيم ضد بعض الجزيئات والكائنات الحية الدقيقة في تعميم الهواء الداخلي [10، 11]. ومع ذلك، فإن أدائها محدود في البيئات المتخصصة مثل عيادات الأسنان، حيث يتم إنشاء قطرات عالية التركيز وقريبة المدى محملة بأحمال بكتيرية كبيرة أثناء العلاج. في البيئات الجراحية لطب الأسنان التي تتميز بمعدل دوران مرتفع للمرضى والعمليات الإجرائية المتكررة، يسهل القرب بين الأطباء والمرضى النشر السريع للقطرات - المدفوعة بقوى التأثير العالي للأدوات العلاجية - في المحيط المباشر لأطباء الأسنان والممرضات. لا تستطيع أجهزة تنقية الهواء التقليدية وحدها تحقيق الإزالة الفعالة وفي الوقت المناسب للقطرات المحمولة بالهواء، ولا يمكنها تمكين الجمع المستهدف والتطهير الفعال لهذه القطرات. وبالتالي، تفشل هذه الأساليب في معالجة انتقال الرذاذ بشكل أساسي أثناء إجراءات طب الأسنان، مما يؤدي إلى إدامة مخاطر العدوى المرتفعة داخل العيادة ويشكل تهديدات صحية كبيرة للأطباء وطاقم التمريض. إن تطوير جهاز تطهير الأسنان القادر على استخلاص الهواء المحمل بالقطرات من فوق تجويف فم المريض يحمل أهمية كبيرة للوقاية الفعالة من العدوى الناتجة عن عمليات علاج الأسنان.
يمثل مطهر الفم MassPhoton، الذي تم تطويره وتصميمه بشكل مستقل بواسطة MassPhoton، أول تكامل لمبادئ ناميك الهواء مع تقنية التطهير بالأشعة فوق البنفسجية LED الخالية من الزئبق في جهاز واحد لتطهير الفم. تستخدم الثنائيات الباعثة للضوء فوق البنفسجي (UV-C LEDs) المستخدمة في عملية التطهير رقائق أشباه الموصلات لتحويل الطاقة الكهربائية إلى ضوء فوق بنفسجي، مما يمثل تقنية تطهير ناشئة. لا تحتوي هذه الرقائق على زئبق ولا تولد أي غازات ضارة مثل الأوزون أثناء عملية التحويل، مما يدل على إمكانية كبيرة لاستبدال الطرق الكيميائية التقليدية ومصابيح الزئبق ومصابيح الزينون في تطهير الهواء والأسطح والماء [12-16]. تنبعث مصابيح LED UV-C من الأشعة فوق البنفسجية في نطاق الطول الموجي 260-280 نانومتر، مما يؤدي إلى تكوين ثنائيات البيريميدين (خاصة الثيمين / اليوراسيل) في الحمض النووي الريبي (DNA) والحمض النووي الريبي (RNA)، وبالتالي تغيير بنية المادة الوراثية وجعل مسببات الأمراض غير قادرة على التكاثر [17]. على عكس طرق التطهير التقليدية التي تعالج الهواء الداخلي ككل، يتيح مطهر الفم MassPhoton إزالة القطران بشكل فوري عند نقطة منشأها. يمنع هذا التصميم بشكل فعال تشتت القطيرات داخل العيادة، مما يقلل بشكل كبير من خطر انتقال العدوى بين مقدمي الرعاية الصحية والمرضى بسبب الأمراض المعدية المنقولة عن طريق الهواء أو الدم.
2 المادة والطريقة
2.1 المواد

الشكل 1. رسم تخطيطي للمنتج والمحاكاة البصرية لمطهر الفم UV-C LED: (أ) عرض ثلاثي الأبعاد؛ (ب) منظر جانبي؛ ( ج ) توزيع كثافة طاقة الأشعة فوق البنفسجية.
تعرض هذه الدراسة التصميم والمحاكاة البصرية لمطهر الفم استنادًا إلى تقنية UV-C LED، كما هو موضح في الشكل 1. يهدف المطهر المصمم خصيصًا لعيادات الأسنان إلى تقليل مخاطر العدوى للعاملين في الرعاية الصحية والمرضى أثناء التشخيص والعلاج عن طريق الفم. يستخدم 275 نانومتر من مصابيح UV-C LED ويتضمن مواد عالية الانعكاس (> انعكاس بنسبة 90٪) في الأعلى لتعزيز تشتت الضوء وتقليل فقدان طاقة الأشعة فوق البنفسجية. تشير عمليات المحاكاة البصرية باستخدام برنامج تتبع الأشعة إلى أن سطح قناة تنقية الهواء يتلقى كثافة من الأشعة فوق البنفسجية تتجاوز 794 وات/سم2، مما يحقق معدل تعقيم بنسبة 99% للإشريكية القولونية في 0.36 ثانية [18]. تم تجهيز مطهر الفم MassPhoton داخليًا بهيكل ترشيح عالي الكفاءة HEPA قادر على التقاط الغبار الجسيمي والمواد العالقة المختلفة ≥0.5 متر، وبالتالي توفير حل مدمج وموفر للطاقة لمكافحة العدوى في البيئات السريرية.
2.2 الطريقة
تم إجراء طرق أخذ العينات وصيغ الحساب المستخدمة في هذه الدراسة وفقًا للملحق D من GB 28235 - المتطلبات الصحية لأجهزة التطهير بالأشعة فوق البنفسجية. يشكل هذا المعيار، الصادر عن إدارة الدولة لتنظيم السوق وإدارة التقييس لجمهورية الصين الشعبية، معيارًا وطنيًا لجمهورية الصين الشعبية، مما يضمن أن الإجراءات التجريبية وحسابات النتائج تتسم بالدقة المهنية والقوة العلمية.
3 النتائج والمناقشات
3.1 شدة الإشعاع فوق البنفسجي
يشير الإشعاع فوق البنفسجي (UV) إلى القوة الإشعاعية للأشعة فوق البنفسجية المتلقاة لكل وحدة مساحة، ويحدد حجمها بشكل مباشر فعالية التعقيم بوساطة الأشعة فوق البنفسجية. قد تفشل الأشعة فوق البنفسجية غير الكافية في تحقيق التطهير المناسب، في حين أن الإشعاع العالي المفرط بشكل مفرط يمكن أن يؤدي إلى هدر الطاقة غير الضروري. ولذلك، فإن تحديد الإشعاع فوق البنفسجي الأمثل للجهاز يشكل أولوية التصميم الأساسية.
كشف الاختبار أنه، بعد فترة إحماء مدتها 5 دقائق، أظهرت حبات UV-C LED المستخدمة داخل جهاز تطهير الأسنان قيم إشعاع تتراوح من 24,368.2 إلى 27,134.5 واط/سم2 عند قياسها على مسافة رأسية قدرها 2 سم مباشرة أسفل مركز المصباح باستخدام مسبار مقياس إشعاع الأشعة فوق البنفسجية، بمتوسط إشعاع يبلغ 25,956.0 واط/سم2 (الجدول 1). تلبي تمامًا متطلبات جرعة الأشعة فوق البنفسجية للتطهير في البيئات السريرية المعاصرة.

3.2 اختبار تسرب الأشعة فوق البنفسجية
معظم الأطوال الموجية للأشعة فوق البنفسجية ضارة بالأنسجة البشرية، ومن المعروف أن الأشعة فوق البنفسجية A وB وC تسبب درجات متفاوتة من تلف الجلد والعين [19-21]. لضمان السلامة، يجب تقليل التعرض للأشعة فوق البنفسجية أو القضاء عليه. قام الباحثون بقياس الإشعاع فوق البنفسجي في المواضع القطرية اليسرى والوسطى واليمنى حول المطهر، على بعد 30 سم عموديًا من الجهاز، بعد الوصول إلى التشغيل المستقر. تم تكرار كل قياس ثلاث مرات للتأكد من الدقة والموثوقية.
توضح النتائج التجريبية الواردة في الجدول 2 أن قيم الإشعاع فوق البنفسجي المقاسة في المواضع اليسرى والوسطى واليمنى على طول المحيط القطري لجهاز تطهير الأسنان، على مسافة عمودية قدرها 30 سم، كلها أقل من عتبة الأمان. تؤكد هذه البيانات أن تسرب الأشعة فوق البنفسجية من الجهاز أثناء التشغيل أقل بكثير من حدود السلامة المقررة، ولا يشكل أي خطر على صحة الإنسان ويتيح التعايش الحقيقي بين الإنسان والآلة. وهذا يضمن السلامة الشاملة للأطباء والمرضى طوال عملية العلاج.

3.3 اختبار فعالية التطهير
أثناء العلاج عن طريق الفم، تولد المقابض عالية السرعة رذاذًا من اللعاب والدم ومواد أخرى، وتختلط مع قطرات الهواء وتبقى معلقة في البيئة السريرية. ولتقييم فعالية المطهر ضد الميكروبات البيئية الشائعة، تم استخدام أساليب أخذ العينات الميكروبية المهنية وزراعتها. تم استخدام الإشريكية القولونية غير المسببة للأمراض (8099) كمؤشر للاختبار. قبل تشغيل المطهر، تم رش معلق الإشريكية القولونية بشكل موحد عند فتحة الشفط. لمحاكاة ظروف العالم الحقيقي، تم استخدام جهاز رش محمول عند المخرج للرش المتقطع (10 ثوانٍ). بعد التشغيل المستقر، قام جهاز تصادم الهواء المنخل المكون من ست مراحل بجمع أعداد مستعمرات الإشريكية القولونية عند فتحات الشفط والمخرج. تم تحضين Sam-ples رأسًا على عقب عند درجة حرارة 36 ± 0.5 درجة مئوية لمدة 48 ساعة، يليها عد المستعمرات.
تشير البيانات من الجدول 3 إلى أن عدد المستعمرات البكتيرية الطبيعية عند مدخل الهواء كان 611 وحدة مستوطنة/م3 (الشكل 2أ). بعد الترشيح والتعقيم بواسطة جهاز تطهير الأسنان، تم تقليل عدد المستعمرات عند منفذ الهواء بشكل كبير إلى 17 وحدة مستوطنة/م3، مما حقق كفاءة تعقيم بنسبة 97.2% (الشكل 2ب). كما هو موضح بوضوح في الشكل 2، فإن عملية الترشيح والتطهير بالجهاز تخفف بشكل فعال من مخاطر العدوى المرتبطة بانتقال الميكروبات، مما يدل على أداء تطهير ممتاز ويمنح وظائف مفيدة في الوقاية من الأمراض المنقولة عبر الهباء الجوي.
الجدول 3. اختبار معدل مبيد الجراثيم E. القولونية.

ويبين الجدول 3 أن فتحة الشفط كانت تحتوي على 611 وحدة تشكيل مستعمرات/م3 قبل التعقيم (الشكل 2أ)، وانخفضت إلى 17 وحدة مستعمرة/م3 بعد العلاج، مما أدى إلى معدل تعقيم قدره 97.22% (الشكل 2ب). ويؤكد الشكل 2 بصريًا قدرة المطهر على تقليل مخاطر انتقال الميكروبات بشكل كبير.
الشكل 2. مقارنة الإشريكية القولونية قبل وبعد التعقيم: (أ) عدد الإشريكية القولونية في الهواء قبل تشغيل المطهر؛ (ب) عدد الإشريكية القولونية بعد عملية المطهر.
3.4 تقييم فعالية مبيد الجراثيم للتلوث الميكروبي
نظرًا لأن فتحة سحب الهواء بالجهاز متجهة لأعلى بينما تكون فتحة العادم موجهة لأسفل، فإن الاختلافات في تدفق الهواء وتوزيع الكائنات الحية الدقيقة المحمولة بالهواء (الكائنات الحية الدقيقة التي تحدث بشكل طبيعي في الهواء، بما في ذلك البكتيريا والفطريات والفطريات الشعاعية) قد تستمر حتى داخل نفس الغرفة. وهذا يمكن أن يؤثر على فعالية التعقيم.
للتأكد من أن النتائج التجريبية تعكس بدقة الأداء الفعلي للجراثيم لجهاز تعقيم الفم، قام الباحثون بجمع عينات الهواء في كل من فتحات السحب والعادم قبل وبعد تنشيط الجهاز. تم تحضين أطباق بتري المجمعة في حاضنة ذات درجة حرارة ثابتة عند 36 ± 0.5 درجة مئوية. بعد الحضانة، لوحظ نمو مستعمرة ميكروبية على الأطباق وقياسها كميا.
تكشف البيانات الواردة في الجدول 4 أنه قبل تشغيل الجهاز، كان عدد مستعمرات البكتيريا الطبيعية عند مدخل الهواء 41 وحدة تشكيل مستعمرات/م3 (الشكل 3أ). عند تنشيط الجهاز، أدى تدفق الهواء إلى تركيز البكتيريا الطبيعية المحيطة بسرعة عند المدخل، مما رفع العدد إلى 133 وحدة تشكيل مستعمرة/م3 (الشكل 3ب) - وهو ما يمثل زيادة بنسبة 224.39% عن قيمة خط الأساس (41 وحدة تشكيل مستعمرة/م3). قبل العملية، كان عدد مستعمرات المخرج 36 وت م/م3 (الشكل 3ج)، ويختلف بمقدار 5 وت م3 فقط عن المدخول (41 وت م3/م3)، مما يؤكد التوزيع الموحد بشكل أساسي للبكتيريا الطبيعية المحمولة جواً. بعد التنشيط، أدى الترشيح والتعقيم عالي الكفاءة إلى خفض عدد المنافذ من 36 وحدة مستوطنة/م3 إلى 5 وحدة مستوطنة/م3 (الشكل ثلاثي الأبعاد) - وهو انخفاض بنسبة 86.11% مقارنة بمستويات ما قبل التشغيل. تكشف المقارنة المباشرة لقيم السحب التشغيلي (133 cfu/m3) والمخرج (5 cfu/m3) عن انخفاض بنسبة 96.24% في المخرج. يعرض الشكل 3 مقارنة مرئية لأعداد المستعمرات البكتيرية الطبيعية قبل وبعد المرور عبر جهاز تطهير الأسنان، مما يدل بوضوح على فعاليته الفائقة للجراثيم وقدرته على توفير بيئة علاجية أكثر أمانًا وموثوقية لمقدمي الرعاية الصحية والمرضى.
الجدول 4. اختبار معدل تعقيم البكتيريا الطبيعية

يشير الجدول 4 إلى أن فتحة الشفط كانت تحتوي على 41 وحدة تشكيل مستعمرة/م3 قبل التشغيل، وتزيد إلى 133 وحدة تشكيل مستعمرة/م3 أثناء التشغيل بسبب تجميع تدفق الهواء (زيادة بنسبة 224.39%). كان لدى المنفذ 36 وحدة تشكيل مستعمرة/م3 قبل ذلك و5 وحدة تشكيل مستعمرة/م3 بعد ذلك، بانخفاض قدره 86.11%. تؤدي مقارنة الشفط (133 وحدة تشكيل مستعمرة/م³) مع المخرج (5 وحدة تشكيل مستعمرة/م³) أثناء التشغيل إلى معدل تعقيم بنسبة 96.24%، كما هو موضح بصريًا في الشكل 3
الشكل 3. مقارنة البكتيريا الطبيعية قبل وبعد التعقيم: (أ) عدد البكتيريا الطبيعية قبل تشغيل المطهر؛ (ب) عدد البكتيريا الطبيعية بعد عملية التطهير.
4 الاستنتاجات
تُظهر المستشفيات حاليًا وعيًا واسع النطاق بالمخاطر المرتبطة بانتقال الأمراض المحمولة جواً وتنفذ التدابير الوقائية بنشاط. ومع ذلك، تظل الحلول الفعالة بعيدة المنال لإدارة الهباء الجوي المتولد أثناء إجراءات طب الأسنان. يدمج جهاز تطهير الأسنان MASSPHOTON بشكل مبتكر الثنائيات الباعثة للضوء فوق البنفسجي (UV-LEDs)، والمواد عالية الانعكاس، وتقنيات الترشيح عالية الكفاءة. تمثل مصابيح LED للأشعة فوق البنفسجية مصدرًا ناشئًا للضوء فوق البنفسجي، حيث توفر مصابيح LED للأشعة فوق البنفسجية فئة C مزايا متميزة مقارنة بمصابيح الأشعة فوق البنفسجية التقليدية القائمة على الزئبق، بما في ذلك التركيبة الخالية من الزئبق، وعدم وجود متطلبات للإحماء، وعمر الخدمة الممتد، والحجم الصغير [22]. تم استخدام سيناريوهات محاكاة لتقييم فعالية مصابيح LED UV-C في القضاء على الجراثيم، مع إجراء اختبارات التشعيع على الكائنات الحية الدقيقة المستهدفة (الإشريكية القولونية) والبكتيريا البيئية التي تحدث بشكل طبيعي. وأظهرت النتائج معدلات تطهير بلغت 97.22% للإشريكية القولونية و96.24% للبكتيريا الطبيعية، مما يشير إلى أداء قوي مضاد للميكروبات ضد مسببات الأمراض المحمولة جواً. طوال فترة التشغيل، لم يظهر الجهاز أي تسرب للأشعة فوق البنفسجية أو توليد الأوزون، وبالتالي ضمان درجة قابلة للقياس من السلامة للمستخدمين. ومن الجدير بالذكر أن الجهاز الذي تم تقييمه في هذه الدراسة لم يخضع بعد للاختبار السريري في المستشفيات.
في المستقبل، سيقوم فريق البحث بتعزيز تطبيق هذا الإنجاز والتحقق من صحته في البيئات السريرية في العالم الحقيقي، مثل أقسام طب الأسنان في المستشفيات. لن تؤدي هذه المبادرة إلى إنشاء بيئة علاجية أكثر أمانًا لمقدمي الرعاية الصحية والمرضى فحسب، بل ستوفر أيضًا أساسًا علميًا أكثر قوة للتقدم في المجالات ذات الصلة.
مراجع
[1]. نونايون، إس إس، وآخرون، تقييم فعالية جهاز تشعيع UVC-LED في الغرفة العلوية في
تعطيل نشاط الإشريكية القولونية المتطايرة تحت نطاقات التطهير المختلفة، وخلط الهواء، وظروف التشعيع. مجلة المواد الخطرة، 2022. 440 (15 أكتوبر): ص. 1-12.
[2]. Allison JR، EDBC، تأثير توصيل وتصميم مبرد قبضة الأسنان عالي السرعة على إنتاج الهباء الجوي والقطيرات. J دنت، 2021 (112:103746. دوى: 10.1016/j.jdent.2021.103746. Epub 2021 13 يوليو. PMID: 34265364.).
[3]. B، P.، جزيئات الهباء الجوي والهباء الحيوي في عيادة الأسنان. Environ Res, 2014(134:405-9. دوى:10.1016/j.envres.2014.06.027. Epub 2014 22 سبتمبر. PMID: 25218707.).
[4]. J.، S.، الهباء الجوي الحيوي للأسنان باعتباره خطرًا مهنيًا في مكان عمل طبيب الأسنان. آن أجريك إنفيرون ميد,
2007(14(2):203-7. بميد: 18247451.).
[5]. بنغ X، XXLY، طرق انتقال فيروس 2019-nCoV والضوابط في ممارسة طب الأسنان. إنت J العلوم عن طريق الفم,
2020(12(1):9. دوى: 10.1038/s41368-020-0075-9. PMID: 32127517؛ PMCID: PMC7054527.).
[6]. Shahdad S، PTHA، فعالية جهاز الكسح خارج الفم في تقليل التلوث بالرش أثناء إجراءات توليد الهباء الجوي للأسنان: دراسة استكشافية. بر دنت ج. 2020 سبتمبر 11: 1 - 10. دوى: 10.1038/s41415-020-2112-7. Epub قبل الطباعة. خطأ مطبعي في: Br Dent J., 2020 (doi: 10.1038/s41415-020-2288-x. PMID: 32918060؛ PMCID: PMC7484927.).
[7]. Ionescu AC، CMFJ، الجوانب الطبوغرافية للتلوث المحمول بالهواء الناجم عن استخدام قبضات الأسنان
في البيئة العملية. J Am Dent Assoc، 2020(151(9):660-667. دوى: 10.1016/j.adaj.2020.06.002. Epub 2020 يوليو 1. PMID: 32854868؛ PMCID: PMC7328555.).
[8]. تاكانابي واي، MYKJ، تشتت الهباء الجوي المتولد أثناء علاج الأسنان. Int J Environ Res الصحة العامة,
2021(18(21):11279. دوي: 10.3390/ijerph182111279. PMID: 34769795؛ PMCID: PMC8583477.).
[9]. Rutala WA, WD، التطهير والتعقيم في مرافق الرعاية الصحية: نظرة عامة والقضايا الحالية.
Infect Dis Clin North Am، 2021(35(3):575-607. دوي: 10.1016/j.idc.2021.04.004. PMID: 34362535.).
[10]. تشانغ بي، LLYX، تحليل طرق تنقية الهواء في غرف العمليات في المستشفيات الصينية. بيوميد الدقة
إنت، 2020(2020:8278943. دوى: 10.1155/2020/8278943. PMID: 32076617؛ PMCID: PMC7016480.).
[11]. حكيم ح، جي سي تي إل، تأثير جهاز تطهير الهواء المستمر المحمي بالأشعة فوق البنفسجية على تقليل الهواء و
التلوث الميكروبي السطحي في وحدة رعاية العيادات الخارجية لأورام الأطفال. Am J Infect Control., 2019(47(10):1248-1254. دوى: 10.1016/j.ajic.2019.03.026. Epub 2019 1 مايو. PMID: 31053372.).
[12]. Beck SE, RHBL، تقييم أداء التطهير باستخدام UVC-LED والتحقق من التآزر المحتمل بين الطول الموجي المزدوج. Water Res، 2017 (109: 207-216. doi: 10.1016/j.watres.2016.11.024. Epub 2016 نوفمبر 7. PMID: 27889622؛ PMCID: PMC6145099.).
[13]. تشانغ إتش، لوس أنجلوس، تقييم أداء التطهير أحادي المرور للأشعة فوق البنفسجية البعيدة المحمولة جواً
الكائنات الحية الدقيقة في تدفقات القناة. Environ Sci Technol، 2022(56(24):17849-17857. دوى: 10.1021/acs.est.2c04861. Epub 2022 5 ديسمبر. PMID: 36469399.).
[14]. Górny RL، GMPA، فعالية الأشعة فوق البنفسجية - C في تعطيل الكائنات الحية الدقيقة على المواد ذات الهياكل السطحية المختلفة. آن أجريك إنفيرون ميد، 2024(31(2):287-293. دوى: 10.26444/aaem/189695. النشر الإلكتروني 2024 25 يونيو. PMID: 38940114.).
[15]. Corson E، PBPA، تعطيل فيروس التهاب الكبد A في محلول ملحي بالفوسفات وعصير التفاح وماء جوز الهند بواسطة 254 نانومتر و 279 نانومتر أنظمة الإضاءة فوق البنفسجية. فود ميكروبيول، 2025 (129:104756. دوى: 10.1016/j.fm.2025.104756. Epub 2025 20 فبراير. PMID: 40086994).
[16]. Labadie، M.، et al.، كثافة الخلية وتكوين المصفوفة خارج الخلية تخفف من حساسية الأغشية الحيوية البكتيرية
تشعيع UVC-LED. علم الأحياء الدقيقة التطبيقي والتكنولوجيا الحيوية، 2024. 108(1).
[17]. Bhardwaj SK، SHDA، التنشيط الضوئي القائم على UVC كأداة فعالة للتحكم في انتقال
فيروسات كورونا. Sci Total Environ، 2021: ص. 792:148548.
[18]. Rocha-Melogno L، XJDM، تقييم تجريبي لنظام تشعيع مبيد للجراثيم بالأشعة فوق البنفسجية على نطاق واسع داخل القناة
لتعطيل الهباء الجوي الحيوي. Sci Total Environ، 2024 (947:174432. doi: 10.1016/j.scitotenv.2024.174432. Epub 2024 Jul 2. PMID: 38960181.).
[19]. إيشيدا، ك.، وآخرون، كاسح الجذور الحرة NSP-116 يحمي ظهارة القرنية من الأشعة فوق البنفسجية فئة A والتعرض للضوء الأزرق LED. النشرة البيولوجية والصيدلانية، 2021. 44(7): ص. 937-946.
[20]. Sathid Aimjongjun، MSNL، مستخلص اللوتين الحريري ومزيجه مع فيتامين E يقلل من الضرر التأكسدي الناتج عن الأشعة فوق البنفسجية فئة B للخلايا الظهارية الصبغية لشبكية العين. مجلة الكيمياء الضوئية والبيولوجيا الضوئية ب: علم الأحياء، 2013. الصفحات 34-41 (المجلد 124).
[21]. يُظهر DJ, B., Far-UVC Light عند 222 نانومتر إمكانات كبيرة لتعطيل مسببات الأمراض المحمولة جواً بأمان وكفاءة في الأماكن الداخلية المحتلة. Photochem Photobiol، 2023(99(3):1047-1050. دوى: 10.1111/php.13739. Epub 2022 نوفمبر 21. PMID: 36330967.).
[22]. Alonzo A. Gabriel، MLPB، القضاء على السالمونيلا المعوية على الأسطح الشائعة الملامسة للأغذية المصنوعة من الفولاذ المقاوم للصدأ باستخدام الأشعة فوق البنفسجية - C ونفاثة بلازما الضغط الجوي. مراقبة الأغذية، 2018. ص 86: ص. 90-100.
ابق على اطلاع بأحدث المستجدات لدينا من أخبار، تقنيات، وفعاليات.